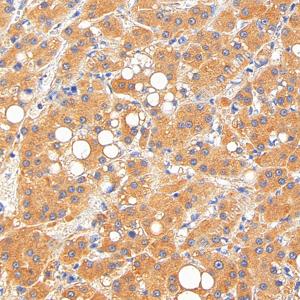
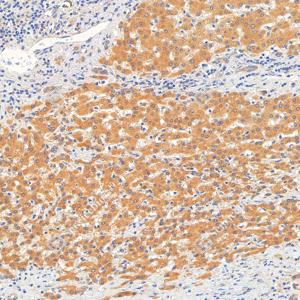

Recombinant Anti-alpha 1 Fetoprotein antibody (Rabbit mAb)
- 100 μL
产品信息
|
蛋白质全称 |
甲胎蛋白 |
|
别名 |
AFP, Alpha 1 fetoprotein, Alpha fetoglobulin, alpha fetoprotein, FETA, HPAFP, AFPD |
|
Uniprot ID |
P02771 |
|
免疫原 |
KLH偶联的人AFP合成肽 |
|
抗体亚型 |
IgG, κ |
|
克隆号 |
SB202 |
|
预测分子量./观测分子量. |
69 kDa / 68-72 kDa |
|
纯化方式 |
亲和纯化 |
|
亚细胞定位 |
分泌型, 细胞质 |
应用
| 应用 | 物种 | 稀释 | 阳性样品 |
| WB 免疫印迹 | 人, 小鼠, 大鼠 | 1: 500-1: 1000 | 胎盘, 肝癌, 肝 |
| IHC/IF 免疫组织化学/免疫荧光 | 人 | 1: 300-1: 1200 | 肝癌, 肝 |
背景
AFP, also known as Alpha-fetoprotein, is a major plasma protein in the fetus and its concentration is very low in the adult. So AFP is usually considered a marker of hepatocyte precursors. AFP can be detected at abnormally high concentrations in hepatocellular carcinomas as well as in the plasma and ascitic fluid of adults with hepatoma. High AFP concentrations have been correlated with tumor cell growth, indicating that AFP can serve as a tumor marker.
图像
|
|
WB检测alpha 1 Fetoprotein蛋白(货号 GB15287). 样品: 经RIPA裂解液(货号G2002)处理的蛋白质. 封闭: 3%脱脂牛奶(货号GC310001)溶于TBST溶液, 室温孵育1小时. —抗: 1: 1000稀释, 4℃ 孵育过夜. 二抗: HRP标记山羊抗兔IgG (H+L) (货号GB23303), 1: 5000稀释, 室温孵育1小时. |
|
|
WB检测alpha 1 Fetoprotein蛋白(货号 GB15287). 样品: 经RIPA裂解液(货号G2002)处理的蛋白质. 封闭: 3%脱脂牛奶(货号GC310001)溶于TBST溶液, 室温孵育1小时. —抗: 1: 1000稀释, 4℃ 孵育过夜. 二抗: HRP标记山羊抗兔IgG (H+L) (货号GB23303), 1: 5000稀释, 室温孵育1小时. |
|
|
IHC检测alpha 1 Fetoprotein蛋白(货号 GB15287). 样品: 人肝癌, 4%多聚甲醛 (货号G1101) 固定12-24小时. 抗原修复: 柠檬酸抗原修复液(干粉, pH 6.0) (G1201), 高压锅均匀喷气计时2分钟. —抗: 1: 500稀释, 4℃ 孵育过夜. 二抗: S-vision免疫组化多聚二抗(山羊抗兔),即用型 (货号G1302), 室温孵育20分钟. |
|
|
IHC检测alpha 1 Fetoprotein蛋白(货号 GB15287). 样品: 人肝, 4%多聚甲醛 (货号G1101) 固定12-24小时. 抗原修复: 柠檬酸抗原修复液(干粉, pH 6.0) (G1201), 高压锅均匀喷气计时2分钟. —抗: 1: 500稀释, 4℃ 孵育过夜. 二抗: S-vision免疫组化多聚二抗(山羊抗兔),即用型 (货号G1302), 室温孵育20分钟. |
|
|
IHC检测alpha 1 Fetoprotein蛋白(货号 GB15287). 样品: 人肝, 4%多聚甲醛 (货号G1101) 固定12-24小时. 抗原修复: 柠檬酸抗原修复液(干粉, pH 6.0) (G1201), 高压锅均匀喷气计时2分钟. —抗: 1: 500稀释, 4℃ 孵育过夜. 二抗: S-vision免疫组化多聚二抗(山羊抗兔),即用型 (货号G1302), 室温孵育20分钟. |
|
|
IF检测alpha 1 Fetoprotein蛋白(货号 GB15287)(绿色). 样品: 人肝癌, 4%多聚甲醛 (货号G1101) 固定12-24小时. 抗原修复: 柠檬酸抗原修复液(干粉, pH 6.0) (G1201), 高压锅均匀喷气计时2分钟. 封闭: 3% BSA(货号GC305010)的PBS溶液, 室温孵育30分钟. —抗: 1: 300稀释, 4℃ 孵育过夜. 二抗: Alexa Fluor 488标记山羊抗兔IgG (H+L) (货号GB25303), 1: 400稀释, 室温孵育1小时. |
|
|
IF检测alpha 1 Fetoprotein蛋白(货号 GB15287)(绿色). 样品: 人肝癌, 4%多聚甲醛 (货号G1101) 固定12-24小时. 抗原修复: 柠檬酸抗原修复液(干粉, pH 6.0) (G1201), 高压锅均匀喷气计时2分钟. 封闭: 3% BSA(货号GC305010)的PBS溶液, 室温孵育30分钟. —抗: 1: 300稀释, 4℃ 孵育过夜. 二抗: Alexa Fluor 488标记山羊抗兔IgG (H+L) (货号GB25303), 1: 400稀释, 室温孵育1小时. |
|
|
IF检测alpha 1 Fetoprotein蛋白(货号 GB15287)(绿色). 样品: 人肝, 4%多聚甲醛 (货号G1101) 固定12-24小时. 抗原修复: 柠檬酸抗原修复液(干粉, pH 6.0) (G1201), 高压锅均匀喷气计时2分钟. 封闭: 3% BSA(货号GC305010)的PBS溶液, 室温孵育30分钟. —抗: 1: 300稀释, 4℃ 孵育过夜. 二抗: Alexa Fluor 488标记山羊抗兔IgG (H+L) (货号GB25303), 1: 400稀释, 室温孵育1小时. |
|
|
IF检测alpha 1 Fetoprotein蛋白(货号 GB15287)(绿色). 样品: 人肝, 4%多聚甲醛 (货号G1101) 固定12-24小时. 抗原修复: 柠檬酸抗原修复液(干粉, pH 6.0) (G1201), 高压锅均匀喷气计时2分钟. 封闭: 3% BSA(货号GC305010)的PBS溶液, 室温孵育30分钟. —抗: 1: 300稀释, 4℃ 孵育过夜. 二抗: Alexa Fluor 488标记山羊抗兔IgG (H+L) (货号GB25303), 1: 400稀释, 室温孵育1小时. |
储存
| 储存条件 | 在-20℃下储存一年, 避免反复冻融. |
| 储存缓冲液 | 含0.15% ProClin300防腐剂, 100 μg/mL牛血清白蛋白和50%甘油的磷酸盐缓冲液. |
注意:
1.本产品仅供研究使用.
2.建议用一抗稀释液(G2025)稀释本产品.
| 货号 | 名称 | 规格 | 价格 | 操作 |
|---|
| 货号 | 名称 | 规格 | 价格 | 操作 |
|---|